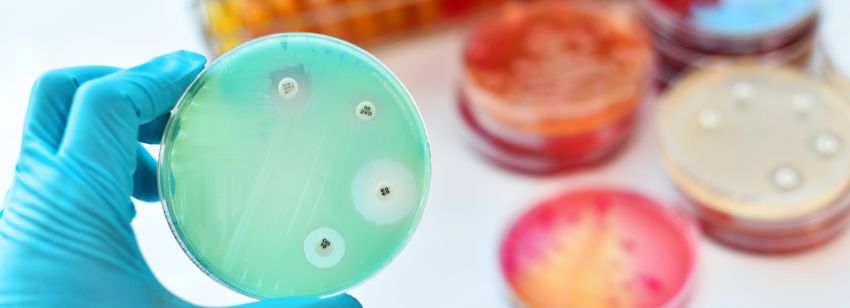

Industrie und Gesetzgeber schaffen Anreize für die Entwicklung neuer Antibiotika
Die Sonderstellung von Reserveantibiotika bei Markteintritt in Deutschland
Am 27. Juli erteilte die Europäische Kommission, wie nach dem bereits positiven Urteil des Ausschusses für Humanarzneimittel (CHMP) der EMA erwartet, Lefamulin die Zulassung. Lemafulin gehört zur neuen Klasse der aus Pilzen gewonnenen Pleuromutilin-Antibiotika und wird bei „Erwachsenen zur Behandlung der ambulant erworbenen Pneumonie (CAP) angewendet, wenn die Anwendung von antibakteriellen Mitteln, die allgemein für die anfängliche Behandlung der CAP empfohlen werden, nicht geeignet ist oder wenn die Behandlung mit diesen erfolglos war". Derartige Meldungen neu zugelassener (Reserve-)Antibiotika sind im Laufe der letzten Jahre leider zunehmend rar geworden.
Auch wenn der Fokus in der Infektiologie gegeben den derzeitigen Umständen auf viralen Erregern wie SARS-CoV-2 liegt, wächst die Bedrohung durch antimikrobielle Resistenzen zunehmend. Um die Fortentwicklung neuer wirksamer Antibiotika sicherzustellen, haben sich mehr als 20 große Pharmafirmen in einer Initiative gegen antimikrobielle Resistenzen (AMR) verbündet und einen umfangreichen Aktionsfonds gegründet. Die Finanzierung ist oft ein kritischer Aspekt, da die Entwicklung äußert risikobehaftet und wenig profitabel ist. Die Absatzzahlen neuer Antibiotika müssen kontrolliert eher gering gehalten werden, um die Ausbreitung neuer Resistenzen zu erschweren und die Wirksamkeit dieser Reserveantibiotika zu erhalten.
-
Das Robert Koch-Institut (RKI) definiert mit dem Bundesinstitut für Arzneimittel und Medizinprodukte (BfArM) eine öffentliche Liste an Kriterien zur Einordnung als „Reserveantibiotikum".
-
Wird dem Antrag des pharmazeutischen Unternehmers auf Freistellung als Reserveantibiotikum stattgegeben, gilt der Zusatznutzen als belegt - das Ausmaß und die therapeutische Bedeutung werden vom G-BA keiner Bewertung unterzogen.
-
Unter Einbezug des RKI und des BfArM legt der G-BA Anforderungen an eine qualitätsgesicherte Anwendung unter Berücksichtigung der Auswirkung auf die Resistenzsituation fest.
Wir bei SKC begrüßen die geplante Änderung der G-BA VerfO und sind auf die praktische Umsetzung und Inanspruchnahme gespannt. Wir analysieren grundsätzliche jegliche Anpassungen des Gesetzgebers und antizipieren die daraus individuell resultierende bestmögliche Strategie für unsere Klienten. Ein umfangreiches Monitoring auf allen Kanälen ist zwingend notwendig, um auch für die Zukunft geplante Anpassungen gesetzlicher Vorgaben frühzeitig hinsichtlich etwaiger Risiken zu beurteilen und individuelle Lösungen zu erarbeiten.
- https://www.ema.europa.eu/en/medicines/human/summaries-opinion/xenleta
- https://ec.europa.eu/health/documents/community-register/2020/20200727148513/anx_148513_de.pdf
- https://www.handelsblatt.com/unternehmen/industrie/antibiotika-forschung-pharmabranche-forciert-mit-milliardenfonds-kampf-gegen-resistente-keime/25990884.html?ticket=ST-20606963-z0ptxyqicw1ot7mPBcXz-ap2
Über den Autor

Director Market Access
M.Sc. Life Science
Fax: +49 511 64 68 14 – 18